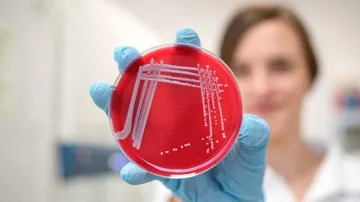
Vzorek bakterií z výzkumu brněnských vědců

Penicilin je sice nejznámějším antibiotikem, ale přestože byl prvním objeveným lékem tohoto typu, nestal se prvním, který se začal využívat. Předstihl ho preparát, který je dnes už v podstatě zapomenutý – Prontosil.
Masově ničit bacily v lidském těle se poprvé v historii podařilo německému vědci Gerhardu Domagkovi. Ve třicátých letech minulého století, kdy někteří výzkumníci úporně pracovali na izolaci čistého penicilinu, studoval Domagk antibakteriální vlastnosti některých barviv. Při tom objevil v roce 1932 sulfonamid Prontosil, který se brzy začal také používat proti infekcím. Představen byl přesně před 90 lety, 15. února 1935. Penicilin, na který narazil skotský lékař Alexander Fleming již v roce 1928, mohl být prakticky využit až během druhé světové války.
V době stále ještě četných hromadných infekcí představoval Prontosil doslova zázrak a vyvolal revoluci v léčbě řady infekčních nemocí bakteriálního původu. S tímto preparátem lidé konečně získali zbraň proti zánětu plic, pohlavním nemocem nebo proti tehdy velmi běžným otravám krve. S výrobou penicilinu a dalších antibiotik význam sulfonamidů sice poklesl, používají se ale dodnes. A to zejména v případech, kdy jsou mikroorganismy vůči antibiotikům odolné.
Domagk byl ve svém hledání univerzálního prostředku proti všem infekčním nemocem velmi důkladný. Jako chemik a lékař dobře věděl, že stav těla je ve značné míře výsledkem fyzikálních a chemických dějů. Imunologie ještě nebyla ve třicátých letech příliš známá, ale Domagk byl přesvědčen o tom, že příroda proti nemocem skrývá i léky. Původně hledal chemické látky, které by ničily vždy jen jeden druh bakterií. Nakonec ale narazil na širokospektrální sulfonamidy – chemikálie, které neškodí lidskému organismu, ale choroboplodné zárodky spolehlivě zabíjejí .
Vánoční objev
Na správné složení tohoto léku přišel Domagk na Vánoce roku 1932. Hned na počátku klinických zkoušek svým Sulfonamidem KL 730 zachránil před amputací infikovanou končetinu vlastní dcery. Nicméně trvalo skoro tři roky, než se přípravek pod obchodním názvem Prontosil objevil na trhu. Lék tehdy vyráběla společnost IG Farben (dnes Bayer), později nechvalně proslulá spojením s vývojem smrtících látek pro nacistické koncentrační tábory.
Prontosil způsobil pozdvižení, protože léčil celou řadu dosud smrtelně nebezpečných infekčních chorob. A mezi prvními zachráněnými byl navíc i syn amerického prezidenta Franklina Roosevelta.
Není divu, že roku 1938 byl Domagk poprvé navržen na Nobelovu cenu. Dostal ji v následujícím roce, bohužel nedlouho po německém židovském novináři Carlu Ossietzkém, což cenu v očích nacistických pohlavárů zcela znehodnotilo. Domagk se tak ocitl ve vězení do doby, dokud cenu nevrátil. Převzít ji mohl až po druhé světové válce, ovšem už bez finanční odměny, která v mezičase propadla.
Z Domagkovy laboratoře později vyšlo několik dalších úspěšných léků, které přispěly například k léčbě obávaných nemocí – rakoviny či tuberkulózy. Chemoterapeutika jsou spolu s antibiotiky dodnes základem léčby infekčních chorob. Ale ani tyto léky nejsou samospásné. To věděl i Domagk, který jednou prohlásil: „Dnes už nejsou hlavními nepřáteli lidí bakterie, ale lidé sami.“